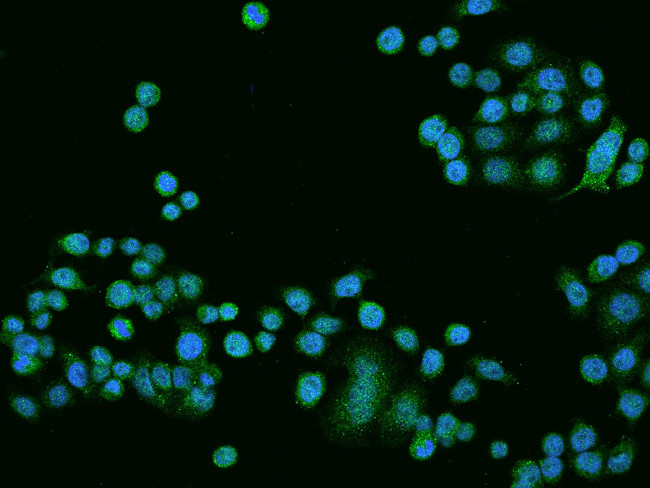
RF1ML Antibody in Immunocytochemistry (ICC/IF)

Search
Invitrogen
RF1ML Polyclonal Antibody
{{$productOrderCtrl.translations['antibody.pdp.commerceCard.promotion.promotions']}}
{{$productOrderCtrl.translations['antibody.pdp.commerceCard.promotion.viewpromo']}}
{{$productOrderCtrl.translations['antibody.pdp.commerceCard.promotion.promocode']}}: {{promo.promoCode}} {{promo.promoTitle}} {{promo.promoDescription}}. {{$productOrderCtrl.translations['antibody.pdp.commerceCard.promotion.learnmore']}}
Additional Information:
{{banner.description}}
图: 1 / 3
RF1ML Antibody (PA5-112181) in ICC/IF
Immunocytochemistry-Immunofluorescence analysis of RF1ML in HT29 cells. Cells were fixed with 4% PFA, permeabilized with 0.1% Triton X-100 in PBS, blocked with 10% serum, and incubated with RF1ML Polyclonal Antibody (Product # PA5-112181) (1:200) at 4°C overnight. Then cells were stained with the Alexa Fluor 488-conjugated Goat Anti-rabbit IgG secondary antibody (green) and counterstained with DAPI (blue). Positive staining was localized to Nucleus and Cytoplasm.



产品信息
PA5-112181
应用
建议稀释比
已发表文章
产品规格
宿主/亚型
Rabbit
/ IgG
分类
Polyclonal
类型
Antibody
抗原
E. coli-derived Human MTRF1L fragment
偶联物
形式
Liquid
浓度
1 mg/mL
保存条件
Store at 4°C short term. For long term storage, store at -20°C, avoiding freeze/thaw cycles.
运输条件
Wet ice
RRID
靶标信息
Mitochondrial peptide chain release factor that directs the termination of translation in response to the peptide chain termination codons UAA and UAG.
仅用于科研。不用于诊断过程。未经明确授权不得转售。
篇参考文献 (0)
您是否在文献中引用过该产品?请点击下方按钮邮件告知我们。